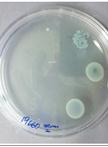
Minimal Bactericidal Concentration for Biofilms (MBC-B)

- Protocols
- Articles and Issues
- About
- Become a Reviewer
Past Issue in 2014
Volume: 4, Issue: 9
Cancer Biology
Transwell Co-culture of Bone Marrow Macrophages with Tumor Cells
Immunostaining Protocol: P-Stat3 (Xenograft and Mice)
Immunostaining Protocol: P-Smad2 (Xenograft and Mice)
Detection of Tumor Cell Surface-reactive Antibodies
Microbiology
Enterovirus 71 Virus Propagation and Purification
Minimal Bactericidal Concentration for Biofilms (MBC-B)
Microfluidic-based Time-kill Kinetic Assay
ELISA for Alpha-hemolysin (Hla) in Methicilin-resistant Staphylococcus aureus (MRSA)
Extraction and Quantification of Poly P, Poly P Analysis by Urea-PAGE
Amino Acid Racemase Enzyme Assays
In vitro Analysis for Macrophage Binding and Pro-inflammatory Responses to Candida albicans
Plant Science
Extraction and Measurement the Activities of Cytosolic Phosphoenolpyruvate Carboxykinase (PEPCK) and Plastidic NADP-dependent Malic Enzyme (ME) on Tomato (Solanum lycopersicum)